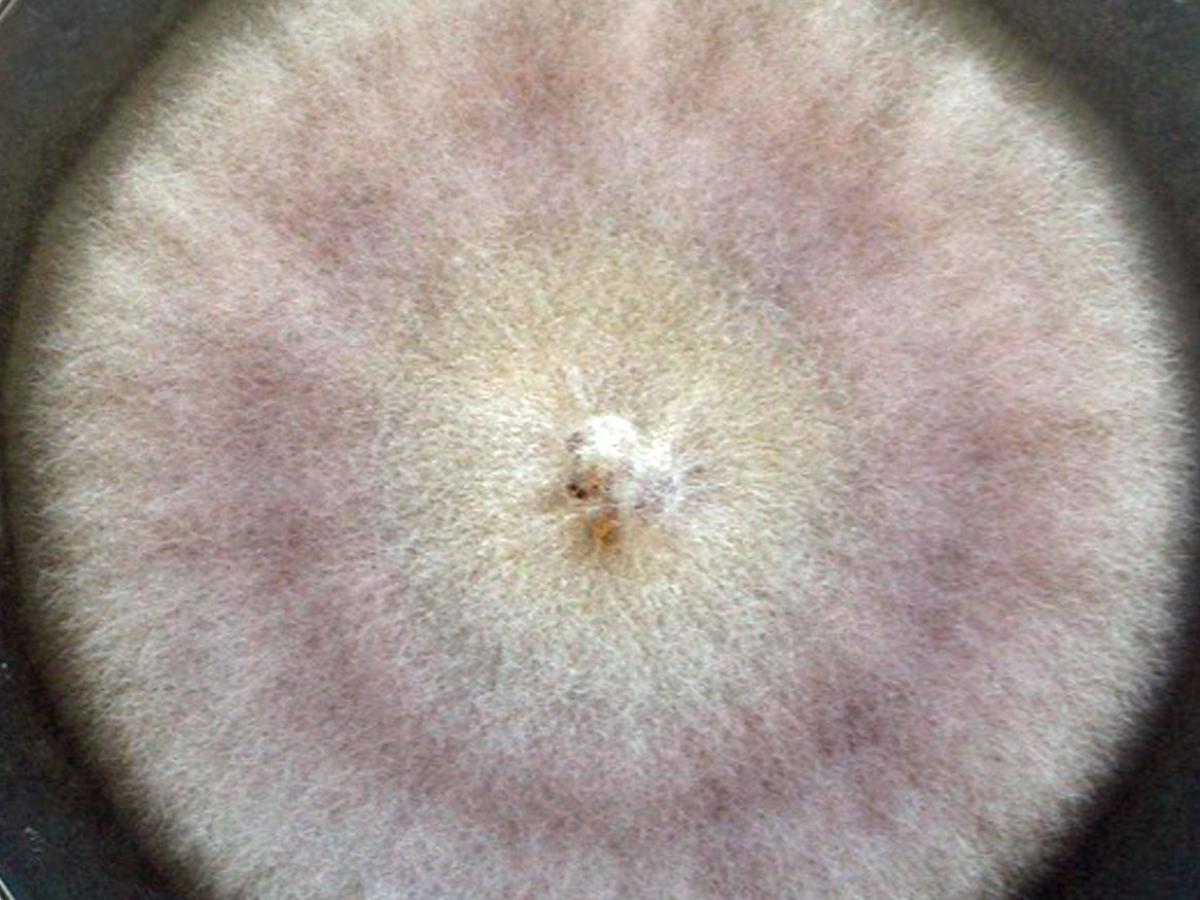
Culture

Status message
Correct! Excellent, you have really done well. Please find additional information below.
Unknown 35 = Cylindrocarpon lichenicola
Culture: Colonies are fast growing, hyaline or bright-coloured, suede-like or woolly. Sporodochia may occasionally be present.
Microscopy: Conidiophores consist of simple or repeatedly verticillate phialides, arranged in brush-like structures. Phialides are cylindrical to subulate, with small collarettes producing hyaline, smooth-walled conidia, which are arranged in slimy masses. Two types of conidia may be produced; macroconidia which are one to several septate, hyaline, straight or curved, cylindrical to fusiform, with a rounded apex and flat base; and microconidia which are one-celled, which are usually clearly distinct from the macroconidia.

Chlamydospores may be present or absent, hyaline to brown, spherical, formed singly, in chains or in clumps, intercalary or terminal.

Comment: The genus contains 35 species, is widespread, isolated mostly from soil and is recorded as an occasional human and animal pathogen. Cylindrocarpon differs from Fusarium by lacking an asymmetrical foot-cell on the macroconidia. RG-2 organism if isolated from humans.
About Cylindrocarpon Back to virtual assessment